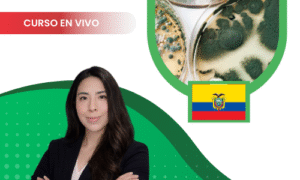

Store
Mostrando 1–12 de 26 resultados
-
Análisis de Datos Aplicado a la Gestión de Residuos Sólidos
Sincronicos El precio original era: $13.00.$10.00El precio actual es: $10.00. Añadir al carrito -
Análisis de diversidad y modelos de nicho para la conservación
Sincronicos El precio original era: $13.00.$10.00El precio actual es: $10.00. Añadir al carrito -
Análisis filogenético y datación molecular de especies
Sincronicos El precio original era: $20.00.$15.00El precio actual es: $15.00. Añadir al carrito -
Análisis taxonómico de biodiversidad
Sincronicos El precio original era: $13.00.$10.00El precio actual es: $10.00. Añadir al carrito -
Bibliometría y visualización científica
Sincronicos El precio original era: $13.00.$10.00El precio actual es: $10.00. Añadir al carrito -
Ecología Molecular Microbiana
Asincronicos El precio original era: $13.00.$10.00El precio actual es: $10.00. Añadir al carrito -
Elaboración de graphical abstracts e infografías científicas
Sincronicos El precio original era: $13.00.$10.00El precio actual es: $10.00. Añadir al carrito -
Evaluación de la Biodiversidad
Sincronicos El precio original era: $13.00.$10.00El precio actual es: $10.00. Añadir al carrito -
Filogenia y reloj evolutivo
Sincronicos El precio original era: $13.00.$10.00El precio actual es: $10.00. Añadir al carrito -
Herpetología
Sincronicos El precio original era: $13.00.$10.00El precio actual es: $10.00. Añadir al carrito -
Introducción a la paleobiología de la conservación
Uncategorized El precio original era: $13.00.$10.00El precio actual es: $10.00. Añadir al carrito